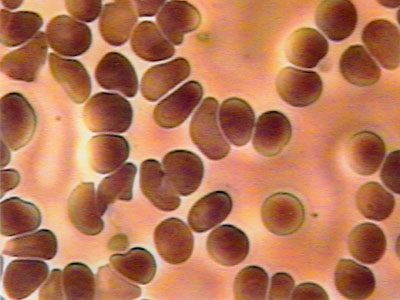

「これは何か悪い冗談でしょう?(笑)」
よく健康番組の類やっている血液サラサラ測定を受ける機会があったので受けてきました。とはいってもテレビのような本格的なやつではなく、指先から血液採取して顕微鏡で覗くという簡易的なもの。結果は理想的なサラサラ状態!チェックシートで行った事前調査ではドロドロまっしぐらコースに該当していたので一体何がどうなっているのか。思わず産業医の先生に聞いたくらい。ひょっとしたらタバコをやめたのが大きいのかもですね。階段で息切れしなくなったし!
よし
これからもモリモリ肉を食べうわなにをするやめr

コメント